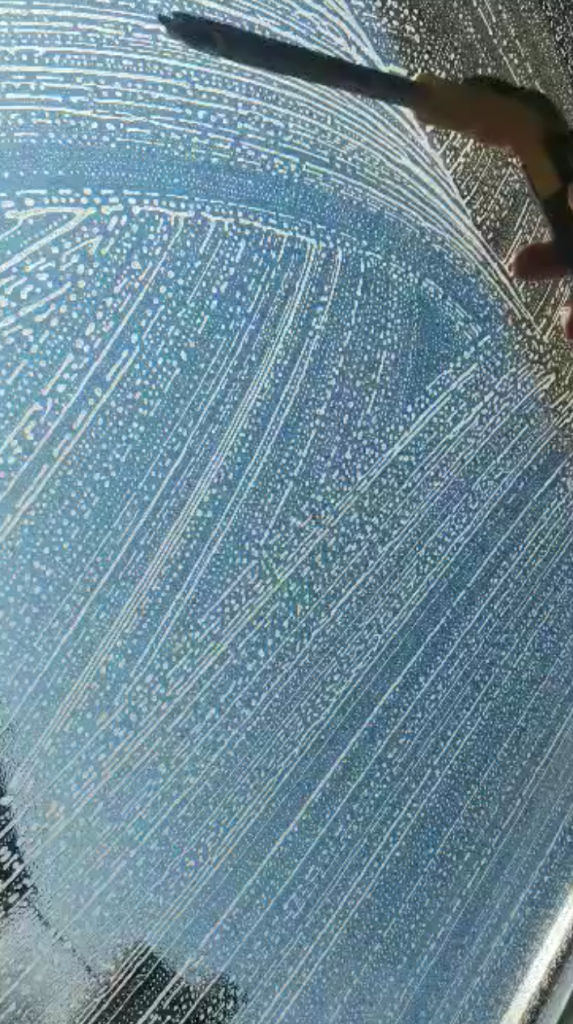

Les services que je propose sont les suivants
Nettoyage des vitres

Nettoyage en nacelle CACES 3A/3B

Nettoyage toiture véranda

Nettoyage des panneaux solaires

Nettoyage d'ehpad

Nettoyage de terrasse au karcher

Nettoyage des parois vitrées

Nettoyage d'école

Nettoyage de Macdo

Nettoyage d'hôtel

Nettoyage d'une vitrine

Nettoyage de lycée

Nettoyage des châssis

Nettoyage des traverses

Nettoyage des gouttières

Nettoyage de haute qualité!
Il est très important pour moi de veiller à ce que vos vitres soient nettoyées dans les règles de l’art. Je suis minutieux et prête attention aux détails afin de vous offrir une vue cristalline.

Entreprise de confiance
Je sais que vous devez faire confiance à votre laveur de vitres. L’excellente réputation que j’ai acquise dans la région est le fruit d’un travail acharné et d’une grande fiabilité. Vous pouvez me faire confiance pour assurer la propreté de vos vitres sans aucun souci.

Prix abordables
Tout devient plus cher, mais nous ne croyons pas à la surfacturation de nos clients. Je maintiens mes prix compétitifs et abordables. Attendez vous à un excellent rapport qualité prix !
Notre zone de service
J’interviens de Calais en passant par St-Omer, Dunkerque, Arneke, Hazebrouck, Armentieres, Lille, Valenciennes, Avesnes sur Helpes et leurs environs 60km au alentour de chaque villes.